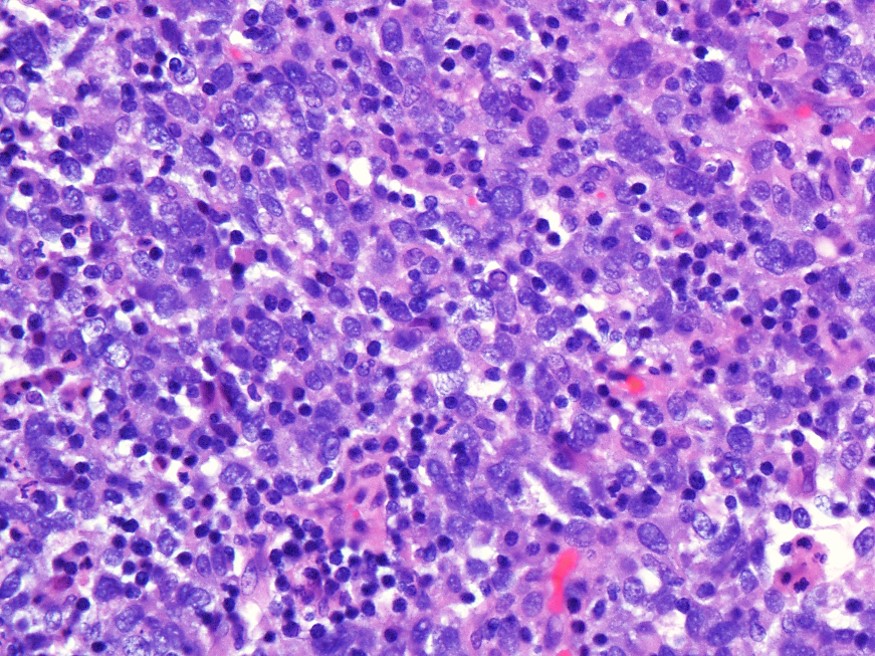

49 yo with breast mass. Hx of breast implants and no cancer. CD45-/CD3-/CD20-/GATA3-/CK7-
49 yo with breast mass. Hx of breast implants and no cancer. CD45-/CD3-/CD20-/GATA3-/CK7-
What's the underlying condition?
- Medullary carcinoma of breast
- Small Lymphocytic lymphoma
- Follicular dendritic cell sarcoma
- Anaplastic large cell lymphoma.
Answer
The answer is C, “Follicular dendritic cell sarcoma”.
Follicular dendritic cell sarcoma occurs predominantly in young to middle-aged adults. The majority of cases arise in lymph nodes, but 1/3 can arise in extranodal sites (e.g. GI tract, soft tissue). Local recurrence occurs in up to 50% of cases, and up to 25% of tumors metastasize. Microscopically, tumor cells are spindled to ovoid in shape with an architecture of sheets, fascicles, or storiform whorls. Cells have indistinct borders with eosinophilic cytoplasm. Nuclei have speckled chromatin. Tumors commonly have a lymphocytic infiltrate. On immunohistochemistry, CD21, CD23, and CD35 are positive. Notably, CD45, CD34, keratins, desmin, CD1a, and HMB45 are negative in these tumors.
Reference: ExpertPath
Contributed by Deniz Peker, M.D.